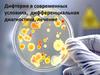
Дифтерия в современных условиях, дифференциальная диагностика, лечение

Similar presentations:
Дифтерия. Эпидемический паротит
1. Дифтерия. Эпидемический паротит.
2. Дифтерия
Острое инфекционноезаболевание с токсическим
поражением ссс, нс, мпс,
местным воспалением с
образованием некротического
фибринозного налета
3. Этиология
• Род Corinebacterium• Вид Corinebacterium
diphtheriae (CD)
• Культуральнобиохимические типы:
– Gravis
– Mitis
•Грам+ палочка.
• Внутри каждого из них
•Растет на кровяном агаре
различают токсигенные и
с добавлением солей
нетоксигенные штаммы
телура.
•Стойкая во внешней
среде
4. Наиболее значимые токсины, определяющие симптомы заболевания:
Экзотоксин
Некротоксин
Гемолизин
Гиалуронидаза
Нейраминидаза
5.
C. diphtheriae хорошо переносятнизкие температуры,
высушивание,
могут сохраняться
в воде и молоке до 20 суток,
в пыли – до 5 недель,
на предметах – до 5 – 6 месяцев без потери патогенных свойств;
Дольше всего они сохраняются в высохших дифтерийных пленках!
C. diphtheriae чувствительны к воздействию
высоких температур и
основных дезинфицирующих средств,
УФ-облучению,
при кипячении погибают за 1 мин.,
в 2 – 3 % растворе хлорамина моментально.
6. Эпидемиология
• Источник – больные, которые становятсязаразными с последнего дня инкубационного
периода в течение последующих 15–25 дней, и
носители токсигенных штаммов коринебактерий.
• Особую опасность представляют пациенты с
дифтерией, протекающими под видом
лакунарной ангины или ринита.
Продолжительность носительства при дифтерии
в среднем составляет 7– 30 дней, но может
продолжаться до 6 мес.
7.
• Основной путь передачи – воздушно-капельный,• Индекс контагиозности – около 20% у не привитых и около 6 %
у привитых.
• Дети
первого
года
жизни
болеют
редко
при
условии
существования у них пассивного иммунитета, полученного от
матери.
• Восприимчивость дифтерии контролируется антитоксическим
иммунитетом.
• Иммунитет после перенесенной дифтерии нестойкий.
• Сезонность: до проведения массовой вакцинации заболевание
чаще возникало в осенне-зимний период. В настоящее время
сезонности возникновения дифтерии не наблюдается.
8. Классификация
По локализацииI.
Дифтерия ротоглотки
Дифтерия гортани
Дифтерия редкой локализации
1.
2.
3.
4.
Носа
Глаз
Уха
Слизистых оболочек полости рта
Кожи
Половых органов
Легких
Пищевода, желудка
Комбинированная дифтерия (поражение нескольких
анатомических отдаленных органов)
9.
АтипичнаяТипичная (с образованием пленчатых
налетов)
II.
III.
Легкая (локализованная дифтерия, за
исключением дифтерии гортани)
Средней тяжести
1.
2.
Распространенная (за исключением
распространенной дифтерии гортани)
Комбинированная
Локализованная дифтерия гортани (ларингит)
Тяжелая
3.
Субтоксическая
Токсическая I, II, III степени
Гипертоксическая
Распространенная дифтерия гортани и трахеи
(трахеоларингит)
Распространенная дифтерия гортани, трахеи и
бронхов (ларинготрахеобронхит)
10. Патогенез
• Входные ворота - слизистые оболочкиротоглотки и носовой полости, реже –
конъюктивальная оболочка, поврежденная
поверхность кожи, слизистые оболочки
половых органов.
• Через 2-4 дня инкубационного периода –
выработка экзотоксина, некротоксина,
гемолизина, гиалуронидазы
• Инкубационный период – 2 сут, до 10 сут.
11. Патогенез
Восаление в месте внедренияпроницаемости сосудов
пропотевание жидкой части крови в ткани и
отёк подлежащих тканей
Вышедший из русла фибриноген плазмы
Превращается в фибрин
тромбокиназа
некротизированных
клеток
Образуется плотная фибриновая пленка на
поверхности слизистых
12. Патогенез
• Регионарные ЛУ – препятствие дляраспространения токсина по всему
организму
• Иммунитет – антитоксический,
противодифтерийный. Классический
гуморальный иммунитет. Не препятствует
носительству токсигенных штаммов
• Поствакцинальный иммунитет полноценен в
течение 5 лет, после 10 лет с момента
вакцинации полностью исчезает
13. Органы-мишени ДТ
• Сердце. Первая мишень.• При локализации ворот в ротоглотке – отек п/к клетчатки
шеи
сброс лимфы с дифтерийным токсином в
лимфотическое русло средостения
далее,
ретроградно, в сердце
• Наибольшая концентрация экзотоксина под эндокардом – в
области проводящей системы (характерное для дифтерии
раннее ее поражение)
• Далее лимфа с ДТ
верхняя полая вена
правое
предсердие
тканевая гипоксия, некротические
изменения кардиомиоцитов, массивная инфильтрация и
резко выраженный отек интерстиция миокарда.
• Быстрое разрастание соединительной ткани на месте
погибших клеток приводит к очаговому кардиосклерозу.
14. Органы-мишени ДТ
• Периферические нервы,расположенные в близости от очага
поражения подвергаются
дегенеративно-воспалительному
процессу с демиелинизацией
• Почки. Инфекционно-токсический
нефроз. Протеинурия, цилиндрурия,
лейко- и эритроцитурия
15. Клинические проявления
• Местные–
–
–
–
–
Пленчатые налеты
Фарингит
Ларингит
Тонзиллит
Регионарная лимфаденопатия
• Распространенные
– Стридор
• Злокачественные
–
–
–
–
–
Плотный отек шеи
Петехии и геморагическое пропитывание слизистых и кожи
Токсический коллапс
ОПН
Миокардит и/или периферические параличи через 1-6 недель от
начала заболевания
16. Локализованные формы
Дифтерия ротоглотки:Катаральная,
Островчатая,
Пленчатая
• Дифтерия ротоглотки:
– Начало – с умеренных
симптомов интоксикации,
вялости, снижение аппетита,
кратковременное (2-4 дня)
повышение t
– Увеличение небных
миндалин и сглаженность их
поверхности
– Не яркая гиперемия с
цианотичным оттенком
слизистой зева
– Фибринозные налеты на
миндалинах, белесоватые с
перламутровым блеском,
снимается с трудом, не
растирается между стеклами
– Увеличение подчелюстных
ЛУ
17. Дифтерия
• Пленчатыеналожения на
миндалинах
18. Локализованные формы
• Дифтерия гортани– Постепенное начало
– Субфебриллитет
– Слабо выраженная интоксикация
– Осиплость голоса
– Сухой кашель
– Затруднение вдоха, одышка, цианоз лица
– Стадии дифтерии гортани
19. Дифтерийный круп
• Дифтерийные пленкирасполагаются на
голосовых связках и
слизистой гортани,
трахеи и бронхов
• Локализованный
• Распространенный (Аларинготрахеит, Б –
ларинготрахеобронхит)
20. Локализованные формы
–Стадии дифтерии гортани:• Катаральная (ст.крупозного кашля).
Грубый, «лающий» кашель, нарастание
осиплости голоса
• Стенотическая. Афония, беззвучный
кашель, шумной дыхание, удлинение
вдоха, втяжение уступчивых мест грудной
клетки, психомоторное возбуждение,
нарастающая гипоксия
• Асфиксическая. Адинамия, сонливость,
поверхностное тахипноэ
21. Дифтерия дыхательной системы
• Дифтеритическая(геморрагическая)
пневмония с
образованием
пленок в бронхиолах
(окраска
гематоксилинэозином)
22. Дифтерия носа
– Заложенность– Серозно-геморрагические
выделения
– Раздражение крыльев
носа и кожи верхней губы
– T тела нормальная
– Интоксикация отсутствует
– Фибринозный налет или
эрозии на слизистой носа
– Чаще односторонний
процесс
23. Локализованные формы
• Дифтерия глаз– Начало острое, t до 38º
– Умеренная отечность век
– Обильное гнойное отделяемое из
глаз
– Серовато-желтые трудно отделяемые
налеты на гиперемированной
конъюнктиве
24. Локализованные формы
• Дифтерия кожи– Чаще у детей первого года жизни
– Поражения на шее, в пах. складках, в
подмышечн. впадинах, за ушной раковиной
– Для детей старшего возраста – поражение
поврежденных участков кожных покровов
(ранки, ссадины и т.д.). Заболевание течет по
типу локализованного процесса или
токсической дифтерии.
– У новорожденных – Д пупочной ранки.
Появляются кровянистые корочки, отечность
околопупочной области. Общая
интоксикация, повышение t тела
25. Локализованные формы
• Дифтерия наружных половых органов– Преимущественно у девочек дошкольного и школьного
возрастов
– Формы: локализованная, распространенная, токсическая
– Гиперемия наружных половых органов с цианотичным
оттенком, фибринозные пленки, регионарная
лимфаденопатия
– При распространенной форме поражение переходит на
промежность и область ануса
– Токсическая ф.: I степень – отек половых губ, II-III степень –
отек п/к клетчатки паховой области, лобка, бедер.
• Дифтерия слизистых оболочек рта
– Плотные б/б бляшки, возвышаются над поверхностью
слизистой, плотно спаяны с подлежащими тканями
26. Токсические формы
• Острое начало, резкий подъем t до 39-40°, ранняяспецифическая интоксикация
• Боль в горле при глотании, боль в области шеи
• Приторно-сладкий запах из полости рта
• Отек небных миндалин с быстрым распространением на
небные дужки, язычок, мягкое и твердое небо, глотку с
развитием фарингеального стеноза
• Плотные фибринозные пленки на небных миндалинах,
быстро распространяющиеся за их пределы
• Значительное (до 3-4 см) регионарных ЛУ
• Отек п/к кл.шеи над увеличенными ЛУ,
распространяющийся на лицо, до ключицы и ниже
• Кровоизлияние на коже и слизистых, носовые
кровотечения, кровоточивость десен
• Симптомы токсического поражения сердца
• ИТШ
27. Токсические формы
• Субтоксическая форма дифтерии ротоглотки– Эдематозная (без отека шеи) – резко выражен
отек мягких тканей ротоглотки при abs отека п/к кл
в области шеи
– С отеком шеи – отек обычно односторонний, в
области регионарных ЛУ
• Токсическая форма дифтерии ротоглотки
– I степень – отек до середины шеи
– II степень – до ключицы
– III степень – ниже ключицы
28. Дифтерия зева
• Токсическаядифтерия зева III ст
– отек шейной
клетчатки и верхней
части груди
29. Токсическая дифтерия зева III ст
30. Токсические формы
• Гипертоксическая форма дифтерииротоглотки
– Геморрагический вариант – как III степень
токсической формы, интоксикация более
выражена
• На 3-5 сут.геморрагический сдр:
– Налеты становятся черными
– На коже – петехии
– Носовые, кишечные, постинъекционные кровотечения
– Молниеносный вариант – быстро нарастают
интоксикация, местный процесс, смерть может
наступить через 3-5 сут
31. Дифтерия
В приемное отделение поступил 16-ти летний
ребенок "цыганской национальности" с жалобами
на боль в горле, выраженную слабость и
припухлость шеи. Болен около 5 дней, за
врачебной помощью не обращался, лечился
дома - обрабатывал зев керосином. Состояние
(со слов родственников) с ухудшением.
Лихорадит до высоких цифр. Прививочный
анамнез сомнительный, т.к. ребенок приезжий, в
предоставленных документах ВСЕ прививки
АКДС написаны одним почерком и одной ручкой.
Высев подтвердил диагноз: распространенная
ДИФТЕРИЯ ротоглотки вызванная C. diphtheriae
gravis, токсическая форма II ст. Пролечен
сывороткой, цефаболом, симптоматическая
терапия... Стацлечение 52 к\д. выписан, из
осложнений - парез мягкого неба.
32. Дифтерия
• Дифтерия. Выраженный отек шеи. Ребенок не можетзакрыть рот. Язык приподнят. Ринит. Субфебрильная
температура. Ребенок погиб от миокардита. Антитоксина не
было. Лаос.
33.
Вероятный диагноз: дифтерия зеваОдна из миндалин покрыта серо-желтой пленкой, которая
распространяется и на противоположную сторону. Края
пленки фестончатые, вокруг нее узкая полоска отечной,
гиперемированной слизистой.
34. Диагностика
• Микробиологические исследования– Посев на селективные среды
– Определение токсигенности выделенных коринебактерий
ПЦР
Клинический анализ крови и мочи
ЭКГ
Прямая ларингоскопия
Иммунология – РПГА, ИФА
– Количественное определение токсина и антитоксина в крови
Стандарт диагностики:
• Патогномоничный признак Д - высев токсигенных
штаммов коринебактерий дифтерии
• Обнаружение дифтерийного токсина в крови
35. Дифференциальный диагноз
• Неспецифические ангины• Паратонзилиты
• Инфекционный мононуклеоз
36. Дифференциальный диагноз
• Лимфаденопатия у 13летнего мальчика,придающая ему вид
человека с «бычьей
шеей».
• Инфекционный
мононуклеоз.
37. Осложнения: поражение сердца
Глухота тонов
Систолический шум
Нарушение проводимости и полная
блокада
1. Ранние миокардиты (до 21 дня после
начала заболевания)
2. Поздние миокардиты (после 21 дня от
начала)
38. Осложнения: периферические параличи
• Типичные проявления дифтерийнойполинейропатии
• Ранние параличи – вялые, атрофия
мышц (n.glossopharingeus (парез мягкого неба,
гнусавость, поперхивание во время еды); n.
oculomotorius (птоз), n.ciliaris (паралич аккомодации)
• Поздние параличи
• Возникают на 3-4 неделе
• По типу полирадикулоневрита, поражение
дыхательной мускулатуры
39. Лечение
• Противодифтерийная сыворотка (ПДС) – дозаопределяется формой дифтерии
• Проба по Безредко: в/к 0,1мл разведенной 1:100
ПДС, ч\з 30 мин п/к 0,1 мл неразведенной
сыворотки. Лечебная доза в/м.
• Эффективность серотерапии оценивается по
положительной клинической динамике состояния
больного в течение 24 – 48 ч.
В случае необходимости повторного введения его
проводят: при локализованной форме через 24
часа, при распространённой – через 12 – 16 часов,
при токсических формах – через 8 – 12 часов.
Сыворотку вводят до исчезновения налётов, но
длительность сывороточной терапии не должна
превышать 2 суток.
40.
• Интенсификация – антибиотикотерапияЛокализованные формы - макролиды;
при токсических – бензилпенициллин,
цефотаксим.
Антибиотики назначаются в обычных средних
дозах курсом на 14 дней.
В ранние сроки заболевания используют
препараты интерферона.
• Сопроводительная – десенсибилизирующие
препараты, витамины группы В, С, орошение
ротоглотки дезинфицирующими средствами
• Синдромальная терапия:
дезинтоксикационная, глюкокортикостероиды,
ингибиторы протеаз, гепарин, ингаляционная
терапия, отсасывание пленок и слизи,
увлажненный кислород, интубация,
трахеотомия.
41. Дозы ПДС
Форма дифтерииЛокализованная Д зева
Островчатая
Пленчатая
Распространенная Д. зева
Токсическая Д. зева
Субтоксическая
Токсическая I степени
Токсическая II степени
Токсическая III степени
Гипертоксическая
Разовая
(тыс. АЕ)
Курсовая
(тыс. АЕ)
10-15
15-30
30-50
10 – 20
30-50
50-70
40-60
60-80
80-100
100-150
150-250
60-100
120-180
До 250
До 450
До 500
42. Дозы ПДС
Форма дифтерииРазовая
(тыс. АЕ)
Курсовая
(тыс. АЕ)
Круп локализованный
Круп распространенный
Д. других локализаций
15-20
30-40
10 -15
30 – 40
60-80 (120)
20-30
•Терапия осложнений
•Строгий постельный режим
Поляризующая смесь
•Кардиомониторирование
Диуретики
•Преднизолон 2 мг/кг/ сутки
Инстенон (Вазодилат)
•Курантил, трентал, рибоксин,
НПВС
•Прозерин, галантамин, дибазол, витамины группы В.С
43. Профилактика
• Дифтерийный анатоксин V1- 3 мес, V2 - 4,5мес., V3 - 6 мес., RV1 18 мес, RV2 7 лет, RV3
14 лет, далее каждые 10 лет
• Вместе со столбнячным анатоксином
(АДСм, АДС)
• В составе комбинированных вакцин (АКДС,
Инфанрикс, Пентаксим, Бубокок и др.)
• Контактным – карантин 7 дней (осмотр,
мазки из зева на BL, лечение)
• Дезинфекция
44.
Контактные подлежат экстренной активной иммунизации взависимости от вакцинального статуса:
•вакцинированным,
но
получившим
последнюю
дозу
анатоксина более 5 лет назад, вводят 1 дозу АДС-М (АД-М);
•непривитым, а также лицам с неизвестным прививочным
анамнезом вводят АДС-М двукратно с интервалом в 45 дней;
•правильно вакцинированные дети, получившие последнюю
дозу анатоксина менее 5 лет назад, ревакцинации не подлежат.
45.
Эпидемический паротит• Острое вирусное заболевание,
характеризующееся общей
интоксикацией, поражением слюнных
желез, реже других железистых органов
и нервной системы
46. Этиология
• Семейство паромиксовирусы• РНК-вирус
• В составе оболочки гемагглютинин,
гемолизин, нейраминидаза.
• Хорошо размножается на куриных
эмбрионах, культурах клеток.
• Устойчив во внешней среде.
47. Эпидемиология
• Антропонозная инфекция• Источник инфекции – больной манифестными и
стертыми, субклиническими формами с конца
инкубационного периода (1-2 дня до клинических
проявлений) до 9 дня болезни.
• Путь передачи – воздушно-капельный в пределах
одной комнаты, при непосредственном контакте,
через предметы обихода, игрушки, внутриутробно.
• Восприимчивость – 85%
• Заболеваемость – дети от 3 до 6 лет, старший
возраст, взрослые
• Иммунитет стойкий.
• Заболеваемость – макс. – осенне-зимний период.
48. Патогенез
Первичнаявирусемия
Возбудитель
Слизистые верхних
дыхательных путей, рта
Железистые
органы
(слюнные)
Вторичная
вирусемия
Другие железистые органы, ЦНС
49. Патогенез
• Воздушно-капельный путь• Входные ворота - слизистые оболочки верхних дыхательных
путей и полости рта
• Вирус реплицируется и накапливается в клетках эпителия
• Затем проникает в кровь (первичная вирусемия) разносится
в различные органы и ткани.
• Гематогенным путем попадает в слюнные железы,
размножается и вызывает местную воспалительную
реакцию.
• вирус взывает поражение других железистых органов (яичек,
поджелудочной железы) и нервной системы
50.
• Больной заразен за несколько часов доначала болезни и в течение 3-5суток
после ее начала
51.
Локализацияпатологического
процесса
• Железы: слюнные
(околоушные,
подчелюстные,
подъязычная),
молочные,
поджелудочная,
половые.
• ЦНС
52. Клиника
• Инкубационный период - от 11 до 23 дней(чаще 15-19 дней)
• продромальный период (1-2 дня) редко
(слабость, разбитость, познабливание,
головная боль, боли в мышцах и суставах,
нарушение сна и аппетита).
• Начало - острое - с повышения
температуры тела до 38-40 °С и
интоксикации организма.
• Лихорадка - 5-7 дней, затем температура
тела литически снижается.
53.
54. Классификация
ТипТяжесть
Течение
Осложнения
Типичная
Железистая
Нервная
Комбинирован
ная
Атипичная
Стертая
Субклиническая
Легкое
Среднетяжелое
Тяжелое
Критерии
тяжести: с-мы
интоксикации,
степень
поражения
железистых
органов
Острое
Неосложненное
(гладкое)
Осложненное
Гипертензионный
синдром
Астенический
синдром
Поражение
черепномозговых нервов
(слуховой –
глухота)
Атрофия яичка
Наслоение
вторичной
инфекции
55. Признаки поражения околоушных слюнных желез
• Припухлость, болезненность при жевании• Увеличенная железа при пальпации мягкая, тестоватой
консистенции, болезненная.
• Болевые точки:
– впереди и позади мочки уха (симптом Филатова)
– в области сосцевидного отростка.
• симптом Мурсона - воспалительная реакция слизистой
оболочки в области выводного протока пораженной
околоушной железы.
• гиперемия и отечность миндалин
• кожа над сл.железой - напряженная, лоснится, отечность
может распространяться на шею.
• болезненность при жевании.
• Увеличение слюнной железы прогрессирует в течение 3 дней,
держится 2-3 дня и затем постепенно (в течение 7-10 дней)
уменьшается.
56.
57.
Эпидемический паротит (свинка):увеличение околоушной железы
Если железа увеличилась
недавно, то это, скорее
всего, вызвано инфекцией:
вирусной (эпидемический
паротит) или
бактериальной.
Рецидивирующее
увеличение слюнной
железы более характерно
для слюннокаменной
болезни (сиалолитиаз),
стойкое увеличение — для
опухолей. Увеличение
околоушных желез у детей
— это почти всегда
эпидемический паротит.
58.
Отверстие выводногопротока околоушной железы
при эпидемическом паротите
(Симптом Мурсона)
Покраснение и отечность в
области протока околоушной
железы (стенонова протока). У
взрослых эпидемический
паротит протекает тяжелее,
чем у детей: панкреатит, орхит,
менингит. При бактериальном
паротите из околоушного
протока может выделяться
гной.
59.
Субмаксиллит - сочетается с поражениемоколоушной сл.железы
Отечность может распространяться на шею
60.
61. Поражение половых желез
Начало – фебрилитет
Интоксикация
Боль
Яичко отечно, уплотнено,
резко болезненно
• М.б.эпидидимит
Острый эпидидимит
Острый орхит
62. Паротитный панкреатит
На 5-7 сутки от начала
В сочетании с поражением др.желез
Боли в эпигастрии
Тошнота
Рвота
температуры
Течение благоприятное
63. Поражение нервной системы
Серозный менингит, менингоэнцефалит
Болеют в 3-10 лет
Серозный менингит на 7-10 сутки
Головная боль
Повышение температуры
Тошнота, рвота
Возбуждение, делирий
Судороги
Менингеальные симптомы
Очаговая симптоматика при менигоэнцефалите
64. Диагностика
Анамнез заболевания и эпиданамнез
Клиническая картина
Клинический анализ крови
Вирусологическое исследование (кровь, слюна,
ликвор).
ИФА
РТГА, РСК (парные сыворотки)
Амилаза крови, диастаза мочи при подозрении на
панкреатит
Спинно-мозговая пункция:
–
–
–
–
–
Ликвор под давлением
Цитоз – 5х106-3х106 кл
Лимфоциты
Белок повышен или в норме
Сахар и хлориды в норме
65. Диф.диагноз – паротит
• Гнойный паротит• Калькулезный сиалоаденит
• Синдром Микулича при мононуклеозе,
лейкозе
• Сиалоаденит при ЦМВ-инфекции
• Р-я на введение живой паротитной вакцины
• Паротит при ВИЧ-инфекции
• Актиномикоз слюнных желез
66.
Диф.диагнозСубмаксиллит
• Лимфадениты
• Периоститы
• Токсическая
дифтерия глотки
Сублингвит
• флегмона дна
полости рта
(ангина Людвига)
67. Диф.диагноз – паротитный менингит
• Серозные менингиты вируснойэтиологии (энтеровирусный,
герпетический и др), бактериальной
этиологии (туберкулезный,
микоплазменный, токсоплазменный,
лептоспирозный, бруцеллезный,
листериозный, орнитозный и др.)
• Гнойные менингиты
68. Лечение
• Режим – постельный 7 – 14 дней.• Дома - дети с легкой и средне-тяжелой формами, с изолированным
поражением околоушных слюнных желез. Госпитализируются дети с
тяжелыми формами, поражением других желез и ЦНС.
• Диета – щадящая.
• Симптоматическое лечение: спазмолитики, анальгетики,
жаропонижающие. Ибупрофен 5-10 мг/кг 4 р/д
Парацетамол 0.1-1 г 4 р/д
• При тяжелом течении: ГКС (преднизолон 1-2 мг/кг/сутки 3-4 дня)
инфузионная терапия (10% р-р глюкозы, витамины группы В).
• При паротите: полоскание рта после еды, сухое тепло местно.
• При серозном менингите: дегидратационная терапия – мочегонные
(Ацетазоламид 250 мг/кг/сут, Фуросемид 3 мг/кг/сут)
• При панкреатите: диета, Спазмолитики (Дротаверин 40-120 мг/кг (1-6
лет), 80-200 мг/кг (6-7лет) 3 р/д №10 или Папаверин 2 г/д №10),
ингибиторы протеолитических ферментов (Апротикин), ферменты
(панкреатин).
• При орхите: суспензорий, в первые 2 – 3 дня холодные примочки,
затем сухое тепло. Постельный режим, ГКС (мазипредон (способствует
инволюции лимфоидной ткани, уменьшает продукцию антител)).
69. Профилактика
• Изоляция больного на 9 дней• Карантин на 21 день (с11 по 21 день при
точном установлении контакта)
• Активная иммунизация живой ослабленной
паротитной вакциной в 12-15 мес, 6 лет.
• Живая аттенуированная паротитная вакцина:
моновакцина, комбинированная вакцина
(Приорикс) V1 в 12-15 мес, V2 в 6 лет.
• Влажная уборка с использование
дез.средств, проветривание.





































































 medicine
medicine